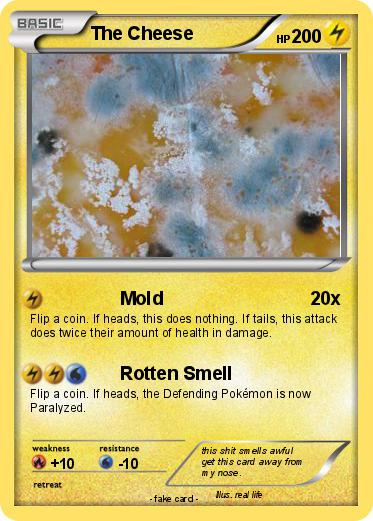
Pokemon The Cheese

Pokemon The Cheese 12
My card
Pokemon Passport
Creation Date : 23 August 2016
Name : The Cheese
Type : Lighting
Attack 1 : Mold
Flip a coin. If heads, this does nothing. If tails, this attack does twice their amount of health in damage.
Attack 2 : Rotten Smell
Flip a coin. If heads, the Defending Pokémon is now Paralyzed.
Comments : this shit smells awful get this card away from my nose.
Illustrator : real life
Related cards









MyPokeCard.com is a funny site to design your own pokemon card, vote for the best pokemon cards and create pokemon colorings